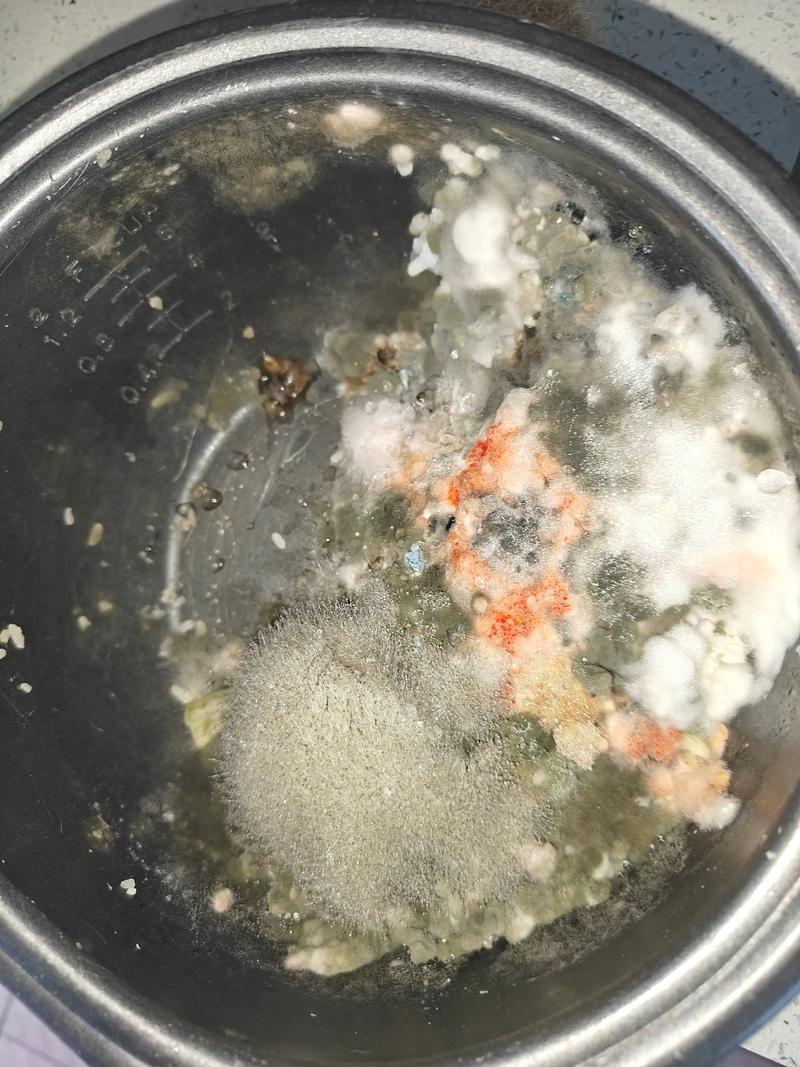

黴菌煮的死嗎:深入解析高溫對黴菌的影響與食品安全指南
Table of Contents
黴菌煮的死嗎?揭開高溫與黴菌毒素的真相
「這食物發霉了,但如果我煮沸或加熱,黴菌是不是就死了,然後就可以安心吃了?」這是一個許多人心中的疑問,也是對食物安全的一大誤解。在日常生活中,我們經常會遇到食物或物品發霉的情況,尤其在台灣潮濕的氣候下更是常見。但高溫,例如煮沸、蒸煮或烘烤,真的能讓發霉的食物變得安全可食嗎?本文將從科學角度深入探討高溫對黴菌的影響,並提供您最正確的食品安全指南。
黴菌是什麼?了解你的「敵人」
首先,讓我們釐清黴菌的本質。黴菌(Mold),屬於真菌界的一種微生物,它透過微小的孢子在空氣中傳播。當這些孢子落在有足夠水分、養分和適宜溫度的物體表面時,就會開始萌芽生長,形成肉眼可見的菌落,也就是我們所說的「發霉」。
- 菌絲(Hyphae): 黴菌生長時會形成線狀的結構,這些菌絲會深入到食物內部,吸收養分。這也是為什麼即使只看到表面一小塊黴菌,其菌絲可能已經遍佈整個食物。
- 孢子(Spores): 這是黴菌的繁殖單位,極其微小且輕盈,可以隨風飄散到各處,是黴菌傳播的主要方式。
- 黴菌毒素(Mycotoxins): 這是黴菌在生長過程中可能產生的一種次級代謝產物。這些毒素對人類和動物具有毒性,可能引起多種健康問題。
高溫對黴菌菌體與孢子的影響:能殺死嗎?
直接回答問題:是的,高溫確實可以殺死或滅活黴菌的菌體和大部分黴菌孢子。
當食物或物品被煮沸、蒸煮、烘烤或經高溫烹調時,高溫會破壞黴菌細胞的蛋白質和細胞結構,使其失去活性,進而達到「殺死」的效果。一般來說,溫度達到攝氏60度以上並持續一段時間,就能有效殺滅大部分黴菌的活體細胞和孢子。這也是為什麼我們常用熱水來消毒餐具,或是將食物煮熟以確保安全。
關鍵點: 高溫能有效殺死黴菌的「生命體」本身,使其無法繼續生長繁殖。
然而,這僅限於黴菌的「生命體」本身。更重要的問題是:殺死黴菌之後,發霉的食物就可以安全食用了嗎?這就涉及到了更深層次的健康風險——黴菌毒素。
煮沸後的「隱形殺手」:黴菌毒素(Mycotoxins)
這正是「黴菌煮的死嗎?」這個問題中最關鍵的環節。即使高溫能殺死黴菌的活體細胞和孢子,但它對於黴菌在生長過程中可能產生的「黴菌毒素」卻幾乎無能為力。
為何黴菌毒素不怕煮?
大多數黴菌毒素是「熱穩定」(heat-stable)的化學物質。這意味著它們的分子結構非常穩定,即使在高溫烹煮、烘烤甚至油炸的條件下,也很難被破壞或分解。例如,著名的黃麴毒素(Aflatoxin),其分解溫度高達280°C以上,遠超過一般家庭烹煮所能達到的溫度。
黴菌毒素的危害
這些看不見、聞不到、也吃不出來的黴菌毒素,一旦進入人體,可能造成多種健康危害:
- 急性中毒: 引起噁心、嘔吐、腹瀉、肝臟損傷等症狀。
- 慢性危害: 長期攝入微量黴菌毒素可能導致免疫力下降、慢性消化道疾病、肝腎功能損害,甚至具有致癌性。例如,黃麴毒素就被世界衛生組織列為一級致癌物,與肝癌的發生密切相關。
- 過敏反應: 對於敏感體質的人,即使是少量黴菌毒素也可能引發過敏反應。
更棘手的是,黴菌的菌絲和其產生的毒素可能已經滲透到食物深層。即使你切除了表面看得見的黴菌部分,食物內部仍可能充滿了肉眼不可見的菌絲和毒素。因此,單純透過烹煮來「消毒」發霉的食物,只是自欺欺人,並無法消除潛在的健康風險。
食物發霉了怎麼辦?切勿「煮」了再吃!
基於上述對黴菌和黴菌毒素的了解,對於發霉的食物,我們的處理原則只有一個:當您對食物的安全性有任何疑慮時,請毫不猶豫地將其丟棄。
以下是一些常見食物的處理建議:
絕對不可食用類(即使切除或加熱)
這類食物因質地鬆軟、水分含量高,黴菌菌絲和毒素極易快速滲透到整個食物內部。
- 麵包、糕點、饅頭: 極易滲透。
- 水果、蔬菜(軟質): 如草莓、桃子、番茄、黃瓜等,水分多,內部容易受污染。
- 優格、酸奶、乳酪(軟質): 如茅屋起司、瑞可達起司等,內部組織細膩。
- 果醬、花生醬、豆製品: 質地濕潤,黴菌菌絲蔓延速度快。
- 熟食、剩菜: 如煮熟的肉類、米飯、麵條、燉菜等,一旦發霉,整份皆應丟棄。
- 堅果類: 如花生、開心果等,特別容易產生黃麴毒素,即使只有一粒發霉,也建議整包丟棄。
建議丟棄類(即使看似可以切除)
雖然這類食物質地較硬,黴菌滲透速度較慢,但為確保健康,仍強烈建議丟棄。
- 起司(硬質): 如帕馬森起司、切達起司等,有時建議可以切掉發霉部分周圍至少2.5公分,但仍有潛在風險。為確保安全,建議直接丟棄。
- 硬香腸、乾式臘腸: 表面可能長有黴菌,但通常為生產過程中故意培養的益菌,可輕輕刮除。若非刻意培養的黴菌,或不確定其性質,仍建議丟棄。
- 蔬菜(硬質): 如胡蘿蔔、高麗菜、甜椒等,可以切掉發霉部分,但建議多切除一些周圍看似完好的部分。若發霉範圍較大或滲透嚴重,請直接丟棄。
黃金法則: 您的健康比任何食物都更珍貴。面對發霉的食物,寧可浪費,不可冒險。不要嘗試透過「煮熟」來解決黴菌問題,因為煮熟只能殺死黴菌本身,卻無法消除其毒素。
如何有效預防黴菌滋生?
與其想著如何處理發霉的食物,不如從源頭預防黴菌滋生。
- 控制濕度: 黴菌在潮濕的環境中生長最快。保持居家環境通風乾燥,特別是廚房、浴室等濕氣較重的地方。使用除濕機、排氣扇可有效降低濕度。
- 低溫保存: 將易腐敗的食物放入冰箱冷藏或冷凍,低溫可以有效抑制黴菌的生長。
- 密封保存: 將食物放入密封容器中,減少與空氣中黴菌孢子的接觸。
- 盡快食用: 食物買回來後,應盡快食用完畢,避免長時間存放。剩菜應在2小時內放入冰箱冷藏,並盡快食用完。
- 定期清潔: 經常清潔冰箱、儲藏櫃、砧板、餐具等,避免食物殘渣成為黴菌的溫床。使用稀釋的漂白水或醋水擦拭,能有效殺滅黴菌。
- 注意包裝: 購買食物時,檢查包裝是否完好,避免購買有破損或膨脹的產品。
居家環境與器皿的黴菌清潔
雖然高溫對食物中的黴菌毒素無效,但對於居家環境或餐具上的黴菌,高溫(如煮沸)或適當的清潔劑則能起到很好的殺菌作用。
砧板與餐具
木質砧板、竹筷等容易吸水且有縫隙的餐具,是黴菌滋生的溫床。定期將其用熱水煮沸10-15分鐘,可以有效殺滅黴菌。塑膠餐具也可用同樣方式消毒,但需注意其耐熱溫度。煮沸後務必瀝乾並徹底晾乾。
牆壁、磁磚、浴室
這些地方的黴菌通常是活體黴菌,可使用稀釋的漂白水(約1:99的漂白水與水)或白醋噴灑後擦拭。清潔時務必戴手套和口罩,並保持通風。清潔後可使用除濕機或保持通風來預防再次發霉。
常見問題(FAQ)
Q1:為何黴菌毒素不怕煮?高溫不是能殺死生物嗎?
A1: 高溫確實能殺死黴菌這種生物體,破壞其細胞結構。然而,黴菌毒素並非活的生物,它們是黴菌在生長過程中產生的一種「化學代謝產物」。這些毒素的化學結構非常穩定,大多數具有「熱穩定性」,即使在沸點以上的高溫下也難以被分解或破壞。這就好比你燒死了一隻蚊子,但牠身上的毒液卻不會消失一樣。
Q2:如何判斷食物上的黴菌是否安全,或是否能切除食用?
A2: 除非是特定種類的硬質起司或風乾肉類(且黴菌類型已知且安全),否則最安全的做法是「只要看到黴菌,就整份丟棄」。尤其對於麵包、水果、蔬菜、優格、果醬和熟食等軟質或高水分食物,黴菌菌絲和毒素會快速滲透到肉眼不可見的深處,任何切除都無法保證安全性。請永遠記得「當有疑慮時,請丟棄」。
Q3:黴菌孢子在空氣中會被高溫殺死嗎?例如烘烤或蒸煮?
A3: 是的,直接暴露於高溫(例如在烤箱內或沸水蒸氣中)的黴菌孢子會被滅活或殺死。這就是為什麼我們用高溫消毒器具。然而,空氣中的黴菌孢子無處不在,即便殺死了特定區域的孢子,新的孢子也可能隨時飄來。因此,重點在於控制濕度、提供清潔的表面,讓孢子無法附著和生長,而不是期望透過高溫來「淨化」整個環境的空氣。
Q4:誤食少量黴菌會對人體造成什麼影響?
A4: 誤食少量黴菌的影響因人而異,取決於黴菌的種類、攝入量以及個人的免疫狀況。大多數情況下,如果只是不小心吃了一小口,可能不會立即產生嚴重症狀,頂多引起輕微的消化道不適,如噁心、腹瀉。但有些黴菌會產生劇毒,長期或大量攝入可能導致嚴重的健康問題,包括過敏反應、肝腎損傷甚至致癌。若出現不適症狀,應及時就醫。
Q5:除了煮沸,還有哪些方法可以去除器皿上的黴菌?
A5: 對於非食物的器皿或表面,除了煮沸消毒,還有其他有效的清潔方法:
- 漂白水: 使用稀釋的家用漂白水(例如1:99的比例)擦拭表面,具有強效的殺菌和去霉效果。使用時請注意通風並戴手套。
- 白醋: 白醋是天然的殺菌劑,將其直接噴灑在黴菌處,靜置數小時後擦拭。它對黴菌孢子也有一定抑制作用,且無化學殘留問題。
- 酒精: 75%的酒精可用於擦拭小面積的黴菌,但通常只對表面黴菌有效。
- 曝曬陽光: 紫外線具有殺菌作用。將可曝曬的物品(如砧板、竹蓆)放在陽光下曝曬,有助於殺滅黴菌並去除濕氣。
- 保持乾燥: 任何清潔後,最重要是確保器皿和表面徹底乾燥,杜絕黴菌再次滋生的條件。